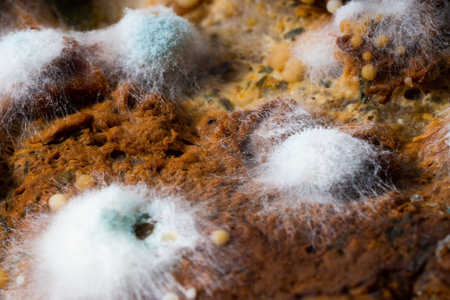
Mold. Nice mold. Mold spores, macro. Mold light, yellow, transparentの写真素材

写真素材 - Mold. Nice mold. Mold spores, macro. Mold light, yellow, transparent
作品情報
Mold. Nice mold. Mold spores, macro. Mold light, yellow, transparent
- ID:257078521
- 作品種別:写真
- 作者名:Oleksandr Kozachok
キーワード
- aging
- background
- bacteria
- bad
- biological
- biology
- bread
- close up
- culture
- damaged
- dangerous
- decay
- dirty
- disease
- expired
- food
- fungal
- fungus
- garbage
- growing
- growth
- harmful
- inedible
- isolated
- macro
- microbes
- microorganism
- microscope
- microscopic
- molded
- molding
- moldy
- mould
- mushrooms
- nature
- old
- organic
- poisonous
- putrid
- rot
- rotten
- spoiled
- spore
- stale
- unhealthy
- waste
- white
類似作品
Macro shot of l...
macro Seeds and...
aphids on a lea...
This close-up o...
Cream cheese ov...
Mold Macro
single fruitfl...
Colony characte...
macro Seeds and...
A detailed view...
Mould bacteria ...
Rhizopus (bread...
Mold Beautiful,...
development of ...
close-up of bac...
Snow and iny wi...
Beautiful and b...
Colorful bubbly...
Green mould bac...
Illusion flow t...
Mold, macro vie...
Extreme close-u...
Surface with ge...
Abstract macro ...
Gene Mutations,...
Water drops on ...
black ants at t...
Ants macro aliv...
Rhizopus (bread...
Encrusting colo...
Mold on pomegra...
Water Condensat...
Close-up of dar...
Microscopic Sil...
Abstract closeu...
macro Seeds and...
Mold Beautiful,...
Mold close-up m...
Mold on the whi...
Mold on pork ca...
Colonies of Pen...
part of a pack ...
Colonies of Pen...
Colony characte...
Backgrounds of ...
fungus on rot f...
Dumplings in bo...
Deep frying fal...
Brown shiny fab...